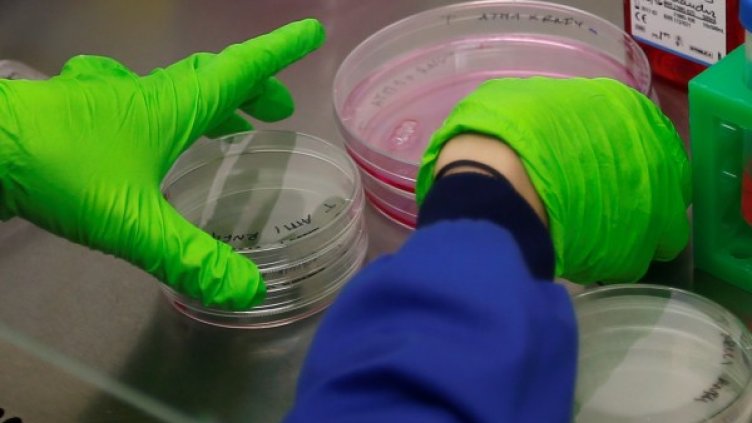
Снимка: архив, Reuters

Корените на рака са в праисторически времена. В пещерите Сварткранс - археоложки обект, на който са открити много находки, учени попаднаха на кост от крак със злокачествен тумор на 1,7 милиона години, съобщи Лента.
Туморът бе идентифициран като остеосарком - агресивен рак на костите.
Учените са на мнение, че костта е от ранни прародители на човека, но не могат да установят за кой точно вид става дума.
На съседния обект Малапа пък учени откриха свидетелства за доброкачествен тумор във фосилизиран прешлен от дете, което е представител на австралопитеците седиба. Прешленът също е на около 2 милиона години. Антрополози отбелязват, че наличието на тумор в задната част на скелета в ранна възраст е рядко срещано и само по себе си е най-древното свидетелство за подобно заболяване у хоминиди.
Двете находки връщат назад във времето появата на злокачествени и доброкачествени тумори у хората.
"Модерната медицина се опитва да докаже, че туморите у хората са свързани със заболявания, които са причинени от съвременния начин на живот - заяви Едуард Оудс от университета Витватерсранд в РЮА. - Изследванията ни обаче разкриват, че тези заболявания са се появили у прародителите ни милиони години преди съществуването на съвременните индустриални общества."
Досега най-древните свидетелства за тумор у прародители на човека се свързваха с фосили от неандерталец, които датират отпреди 120 000 години.
Учените използвали скенер, за да диагностицират и опишат двата тумора.
За двете находки съобщава South African Journal of Science.
/БТА/
Това се случи Dnes, за важното през деня ни последвайте и в Google News Showcase.

Невен Дилков: Нискоорбиталните спътници позволяват да се работи с много по-евтини технологии
Невен Дилков: Нискоорбиталните спътници позволяват да се работи с много по-евтини технологии  Хонконг изпревари Швейцария като най-големия център за трансгранично богатство в света
Хонконг изпревари Швейцария като най-големия център за трансгранично богатство в света  ByteDance обмисля разходи за 70 млрд. долара за развитие на изкуствен интелект
ByteDance обмисля разходи за 70 млрд. долара за развитие на изкуствен интелект  Промени в закона за особения управител повдигат въпрос за риск от искове от "Лукойл"
Промени в закона за особения управител повдигат въпрос за риск от искове от "Лукойл"  Анализаторите на Goldman повишиха целта си за индекса S&P 500 до 8000 пункта
Анализаторите на Goldman повишиха целта си за индекса S&P 500 до 8000 пункта  Нов модел с пазарни индекси заменя минималната доходност на пенсионните фондове
Нов модел с пазарни индекси заменя минималната доходност на пенсионните фондове 
 "Убийство с особена жестокост“: Има задържан за смъртта на мъж в село Ямна
"Убийство с особена жестокост“: Има задържан за смъртта на мъж в село Ямна  Новият премиер на Унгария оряза заплатата си наполовина
Новият премиер на Унгария оряза заплатата си наполовина  Трагедия в Серес: 10-годишно момченце загуби живота си в напоителен канал
Трагедия в Серес: 10-годишно момченце загуби живота си в напоителен канал  "Изравняват всичко като в Газа": Страх, терор и военен контрол в Ливан
"Изравняват всичко като в Газа": Страх, терор и военен контрол в Ливан  Радев: Оставката на Сарафов е само начало на оздравяване
Радев: Оставката на Сарафов е само начало на оздравяване  Пуснаха от ареста студента, обвинен за смъртта на момиче в Благоевград
Пуснаха от ареста студента, обвинен за смъртта на момиче в Благоевград 
 Следва ли резил? Куман с любопитен състав за Мондиал 2026
Следва ли резил? Куман с любопитен състав за Мондиал 2026  SENSHI 31 Gladiators: Пълна бойна карта
SENSHI 31 Gladiators: Пълна бойна карта  Вижте датите и часовете: БНТ излъчва всички 104 мача от Мондиал 2026
Вижте датите и часовете: БНТ излъчва всички 104 мача от Мондиал 2026  Каспер Шмайхел се отказа от футбола
Каспер Шмайхел се отказа от футбола  Барса вади 20 млн. за новия Неймар
Барса вади 20 млн. за новия Неймар  Става страшно в ЦСКА: Сектор "Г" се разграничи от Ицо Янев!
Става страшно в ЦСКА: Сектор "Г" се разграничи от Ицо Янев! 
 Искате нова кариера? Първо изградете тези умения
Искате нова кариера? Първо изградете тези умения  AI, критично мислене и липсата на кадри – какво очертаха експертите в „Бъдещето: От образование до кариера“
AI, критично мислене и липсата на кадри – какво очертаха експертите в „Бъдещето: От образование до кариера“  Пълнолуние в Стрелец на 31 май: Емоциите се повишават, старото си отива
Пълнолуние в Стрелец на 31 май: Емоциите се повишават, старото си отива  Лесен кекс за Черешова задушница (рецепта)
Лесен кекс за Черешова задушница (рецепта)  Защо връзките след 40 са по-сложни, но и по-здрави
Защо връзките след 40 са по-сложни, но и по-здрави  „Повече йод“ не означава по-здрави: какво съветват ендокринолозите
„Повече йод“ не означава по-здрави: какво съветват ендокринолозите 
 продава, Парцел, 650 m2 Стара Загора, кв. Индустриален, Индустриална зона - Запад, 110500 EUR
продава, Парцел, 650 m2 Стара Загора, кв. Индустриален, Индустриална зона - Запад, 110500 EUR  продава, Двустаен апартамент, 74 m2 Стара Загора, Железник, кв. Железник - Запад, 122000 EUR
продава, Двустаен апартамент, 74 m2 Стара Загора, Железник, кв. Железник - Запад, 122000 EUR  продава, Парцел, 2368 m2 Стара Загора, Самара 2, 170740 EUR
продава, Парцел, 2368 m2 Стара Загора, Самара 2, 170740 EUR  продава, Парцел, 2503 m2 Стара Загора, Самара 2, 206300 EUR
продава, Парцел, 2503 m2 Стара Загора, Самара 2, 206300 EUR  продава, Парцел, 699 m2 Стара Загора, кв. Индустриален, Индустриална зона - Запад, 54000 EUR
продава, Парцел, 699 m2 Стара Загора, кв. Индустриален, Индустриална зона - Запад, 54000 EUR  продава, Двустаен апартамент, 56 m2 Стара Загора, Център, 98000 EUR
продава, Двустаен апартамент, 56 m2 Стара Загора, Център, 98000 EUR 
 Премиерът: България и Франция споделят общи позиции за сигурността и диверсификацията на енергийните доставки
Премиерът: България и Франция споделят общи позиции за сигурността и диверсификацията на енергийните доставки  ГЕРБ-Варна: Строителството в „Баба Алино” започна през мандата на Коцев
ГЕРБ-Варна: Строителството в „Баба Алино” започна през мандата на Коцев  Радев: Случаят с незаконния град във Варна е обвързан с процеси, насочени срещу националната ни сигурност
Радев: Случаят с незаконния град във Варна е обвързан с процеси, насочени срещу националната ни сигурност  Освободиха задържания студент за трагедията в Благоевград
Освободиха задържания студент за трагедията в Благоевград  SENSHI 31 Gladiators: Пълна бойна карта
SENSHI 31 Gladiators: Пълна бойна карта  Програма за излъчването на мачовете от световно първенство по футбол 2026 по ТВ
Програма за излъчването на мачовете от световно първенство по футбол 2026 по ТВ 
 Redwire достави на ЕКА прототип на роботизирана ръка за лунния модул Argonaut
Redwire достави на ЕКА прототип на роботизирана ръка за лунния модул Argonaut  Ще има ли геомагнитни бури до края на май: Прогноза за космическото време
Ще има ли геомагнитни бури до края на май: Прогноза за космическото време  НАСА планира изграждането на лунна база с размерите на град
НАСА планира изграждането на лунна база с размерите на град  Двама от членовете на руския екипаж на МКС излизат в открития космос
Двама от членовете на руския екипаж на МКС излизат в открития космос  Най-мощният руски ядрен реактор достигна ключов етап след влизане в експлоатация
Най-мощният руски ядрен реактор достигна ключов етап след влизане в експлоатация  SpaceX избра криптомилиардер за командир на първата си пилотирана мисия до Марс
SpaceX избра криптомилиардер за командир на първата си пилотирана мисия до Марс 










